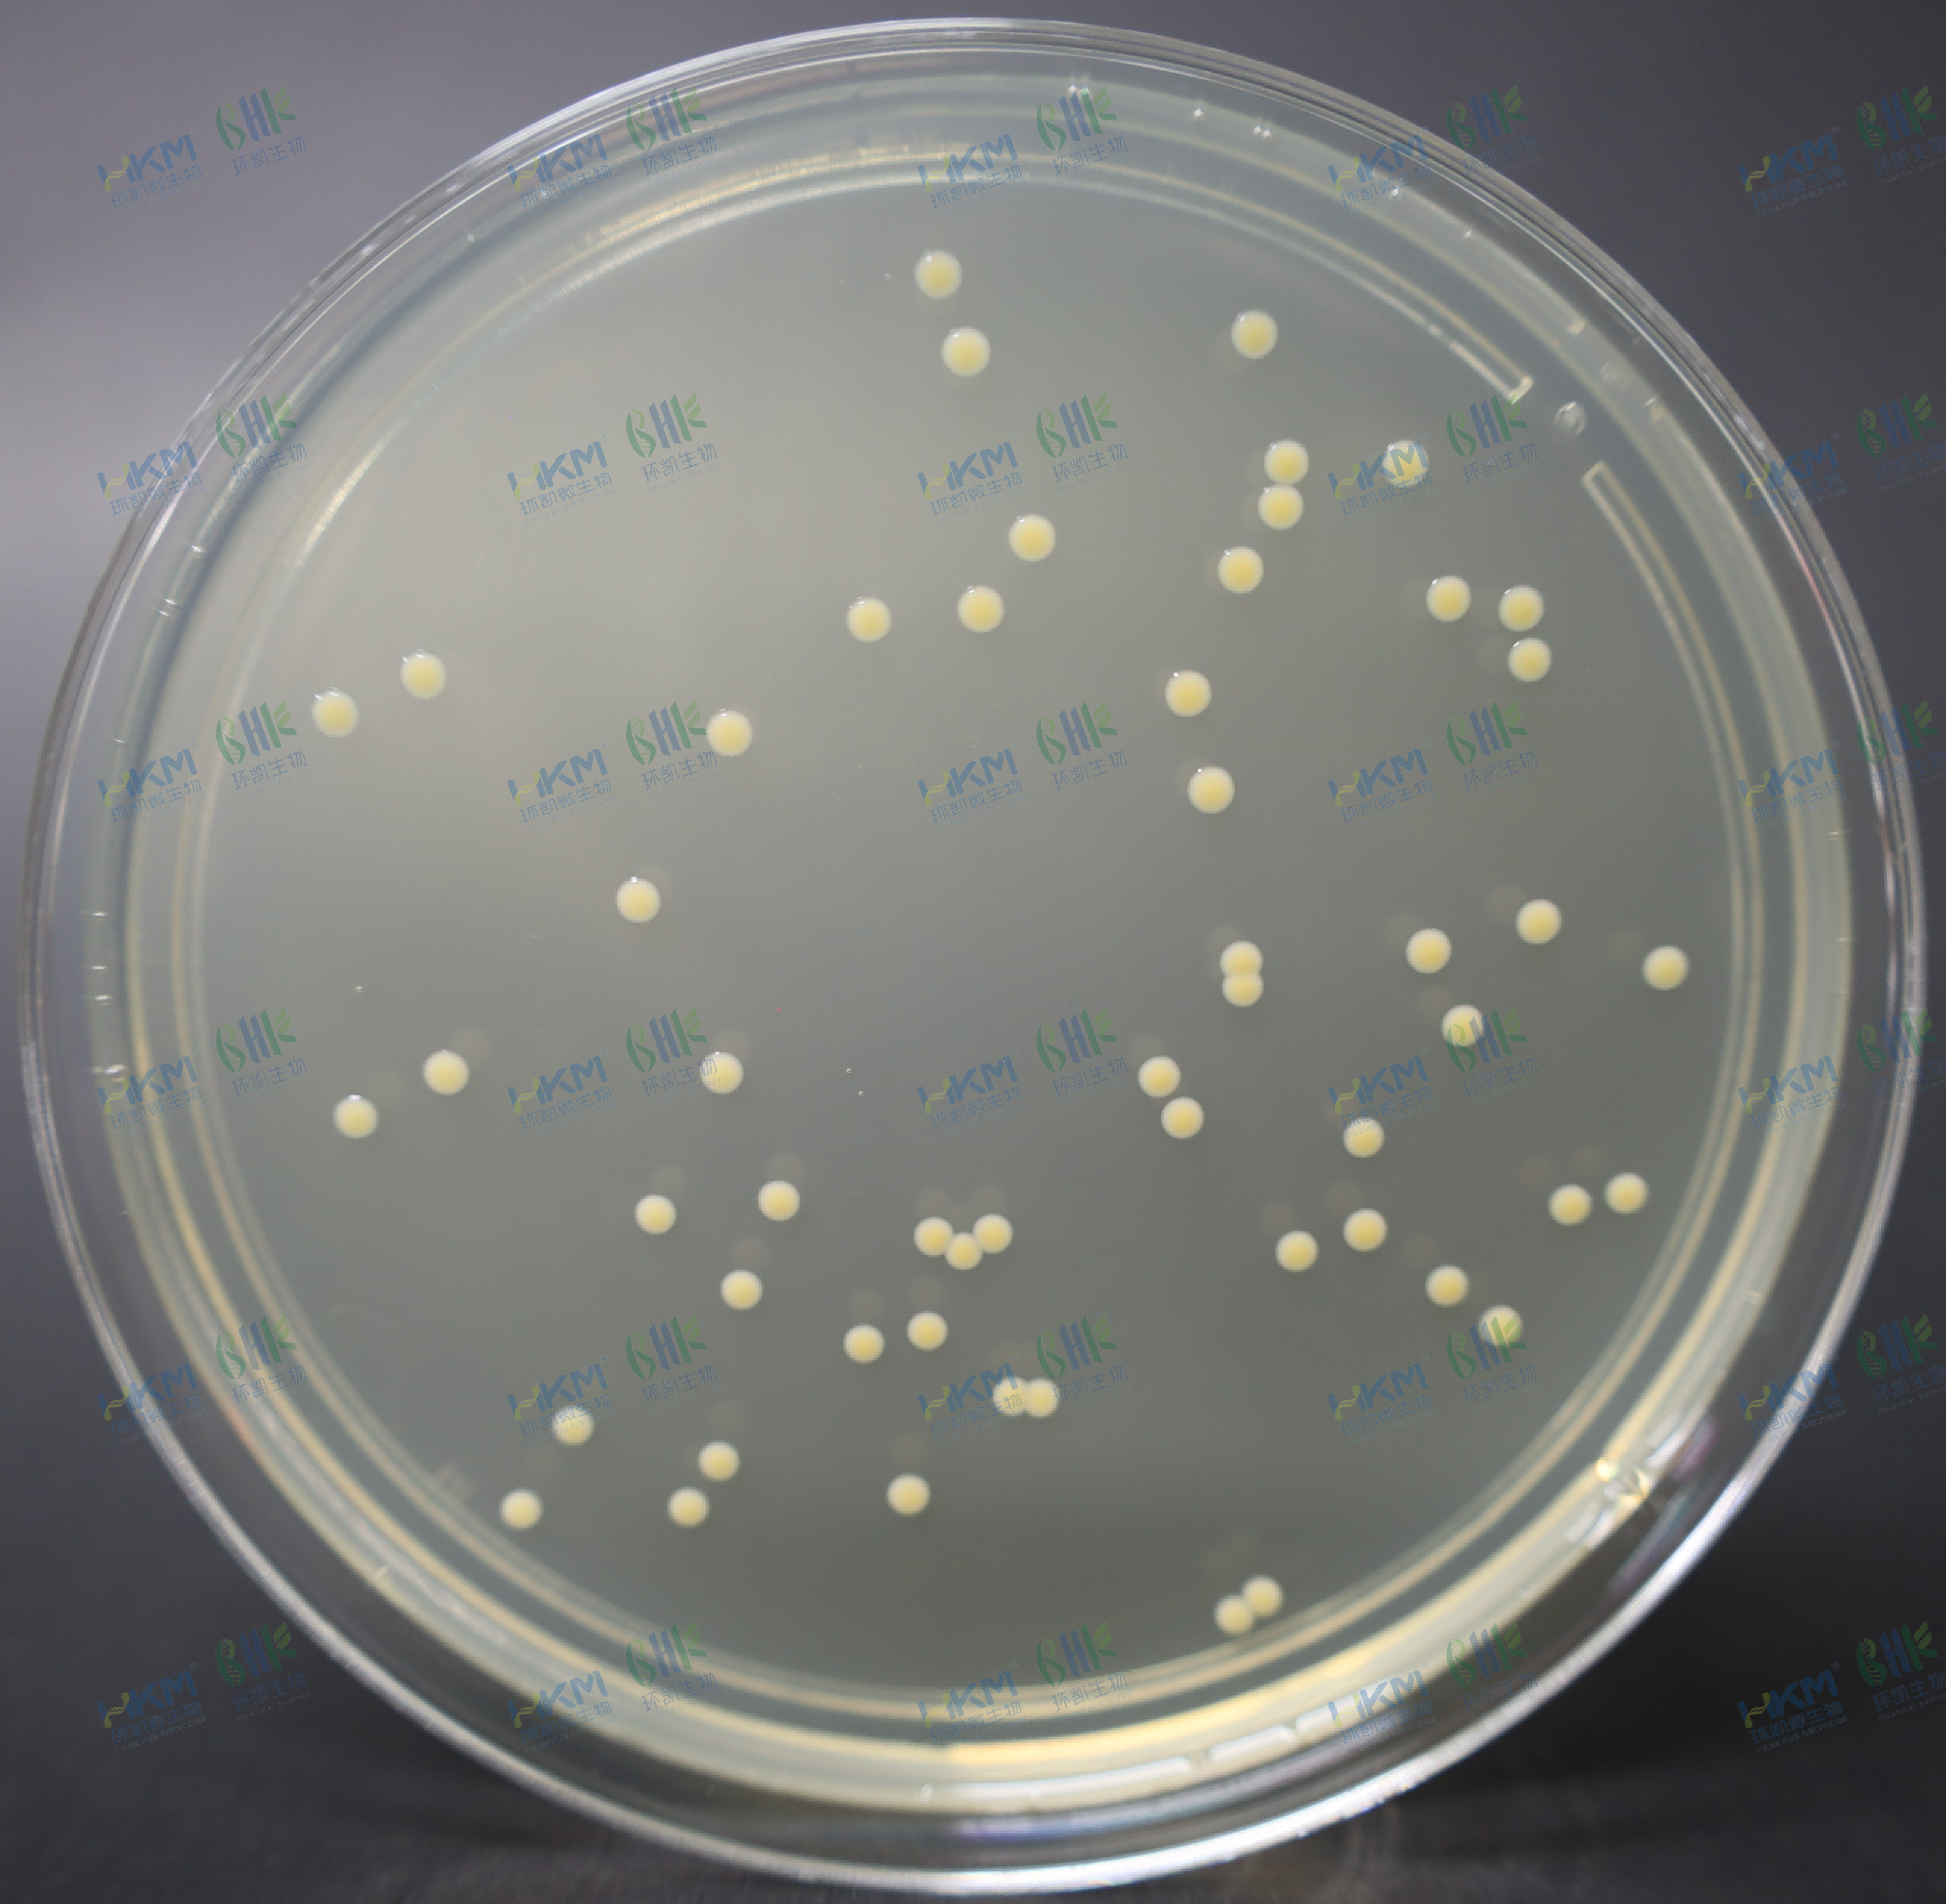

静脉曲张不治会有什么严重后果
严重血液循环受到严重阻碍,导致皮肤营养不足而死亡可能出现伤口溃烂,甚至溃疡到无法被治愈的程度静脉曲张的治疗与预防治疗对于静脉曲张的治疗,应根据病情严重程度选择合适的方法轻微和中度的静脉曲张可以通过改变生活方式穿着压力...
怎么确定自己是不是扁平足呢
1、可以通过症状观察足印法自测以及医学检查来判断自己是否为扁平足具体方法如下症状观察若在活动时足中部出现疼痛,且疼痛向上蔓延,尤其在长时间站立后加重,可能提示扁平足同时,若伴有足跟外翻脚跟向外倾斜足纵弓低平脚底内侧弧...
西藏九芝堂六味地黄丸
1 九芝堂六味地黄丸品牌知名度较高,广告推广较为广泛,因此在市场上的知名度更大2 在产品有效期限上,孙真人的六味地黄丸有效期为五年,而九芝堂的有效期为三年3 孙真人的六味地黄丸原材料来自于被誉为“四大怀药”之乡的地区...
吃什么会有助于长高?
1、1 鱼类其中沙丁鱼含的蛋白质最为丰富另外也可以食用鱿鱼鲍鱼鲤鱼和含钙磷比较丰富的鱼松等2 牛奶牛奶中含有丰富的蛋白质氨基酸钙磷等,对增高极为有利4 柑桔类水果柑桔中含丰富的维生素AB1C含量分别是苹果的3倍,每天...
尿毒症都是怎么引起的
一基础病因慢性肾脏疾病未控制尿毒症是慢性肾衰竭的终末期表现,常见诱因包括原发性肾小球疾病如IgA肾病膜性肾病糖尿病肾病高血压肾病多囊肾等这些疾病导致肾单位进行性破坏,当超过90%的肾单位丧失功能时,肾脏无法完成排泄代...

京公网安备11000000000001号
京公网安备11000000000001号 京ICP备11000001号
京ICP备11000001号